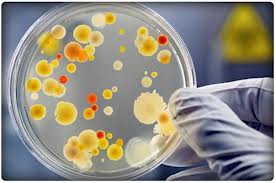
Синдром иммунодефицита у детей Синдром иммунодефицита у детей

Нарушения функционирования иммунной системы могут приводить к синдрому иммунодефицита — состоянию, при котором понижены или отсутствуют адекватные иммунные ответы организма на внедрение чужеродных веществ или возбудителей заболеваний.
Патология может быть врожденной (первичной) или приобретенной (вторичной) и затрагивать как специфическую, так и неспецифическую иммунную систему.
Наиболее важным симптомом этой патологии является сильно выраженная подвержденность инфекционным заболеваниям. Дополнительные симптомы – склонность организма к развитию аутоиммунных реакций, аллергических реакций.
Врожденные (первичные) иммунодефициты
Причиной является нарушение в развитии и созревании клеток иммунной системы (иммунокомпетентных клеток) или ферментный (энзимный) дефект.
Могут проявляться уже в детском возрасте (часто – в первый год жизни), реже – в подростковом возрасте, и крайне редко — во взрослом возрасте. Согласно последним данным, первичные иммунодефициты не являются редким заболеванием, как это считалось ранее. По отдельным формам (например, селективный дефицит иммуноглобулина А) заболеваемость может достигать частоты 1/500 населения.
При недостаточном продуцировании или отсутствии продуцирования антител наблюдается увеличение подверженности бактериальным инфекциям. При нарушениях клеточно-опосредованного иммунитета снижается барьер для вирусных и паразитарных инфекций. При комбинированных дефицитах, затрагивающих многие звенья иммунной системы, прогноз неблагоприятный.
Когда можно заподозрить, что у ребенка нарушение иммунитета?
Врожденные формы имеют ряд внешних признаков, при появлении которых необходима консультация детского иммунолога.
1. Здоровый ребенок на протяжении 10 лет может страдать частыми ОРВИ, отитами, гастроэнтеритами, но обычно хорошо переносит эти инфекции. Дети с иммунодефицитом переносят инфекционные заболевания весьма тяжело, долго, и обычная терапия оказывается недостаточно эффективной.
2. Дети с врожденной формой дефицита часто (но не обязательно) отстают в развитии (рост, вес, развитие навыков).
Для детей с врожденной формой характерна частая кожная сыпь в первый год жизни.
Приобретенный (вторичный) иммунодефицит
Причиной появления приобретенного (вторичного) иммунодефицита является заболевание, оказывающее прямое или косвенное влияние на иммунную систему. Источником нарушений могут быть заболевания органов иммунной системы (например, заболевания крови типа лейкемии) или недостаток иммунокомпетентных клеток (например, повышенная потеря антител при невротических синдромах, уменьшении клеточно-опосредованого иммунитета при СПИДе).
Состояние иммунодефицита может быть вызвано искусственным путем (т.н. иммуносупрессия). Это требуется при лечении некоторых заболеваний (например, аутоиммунных) или при операциях трансплантации (для предотвращения отторжения).
Детская поликлиника Восточный округ, «Маркушка».


































